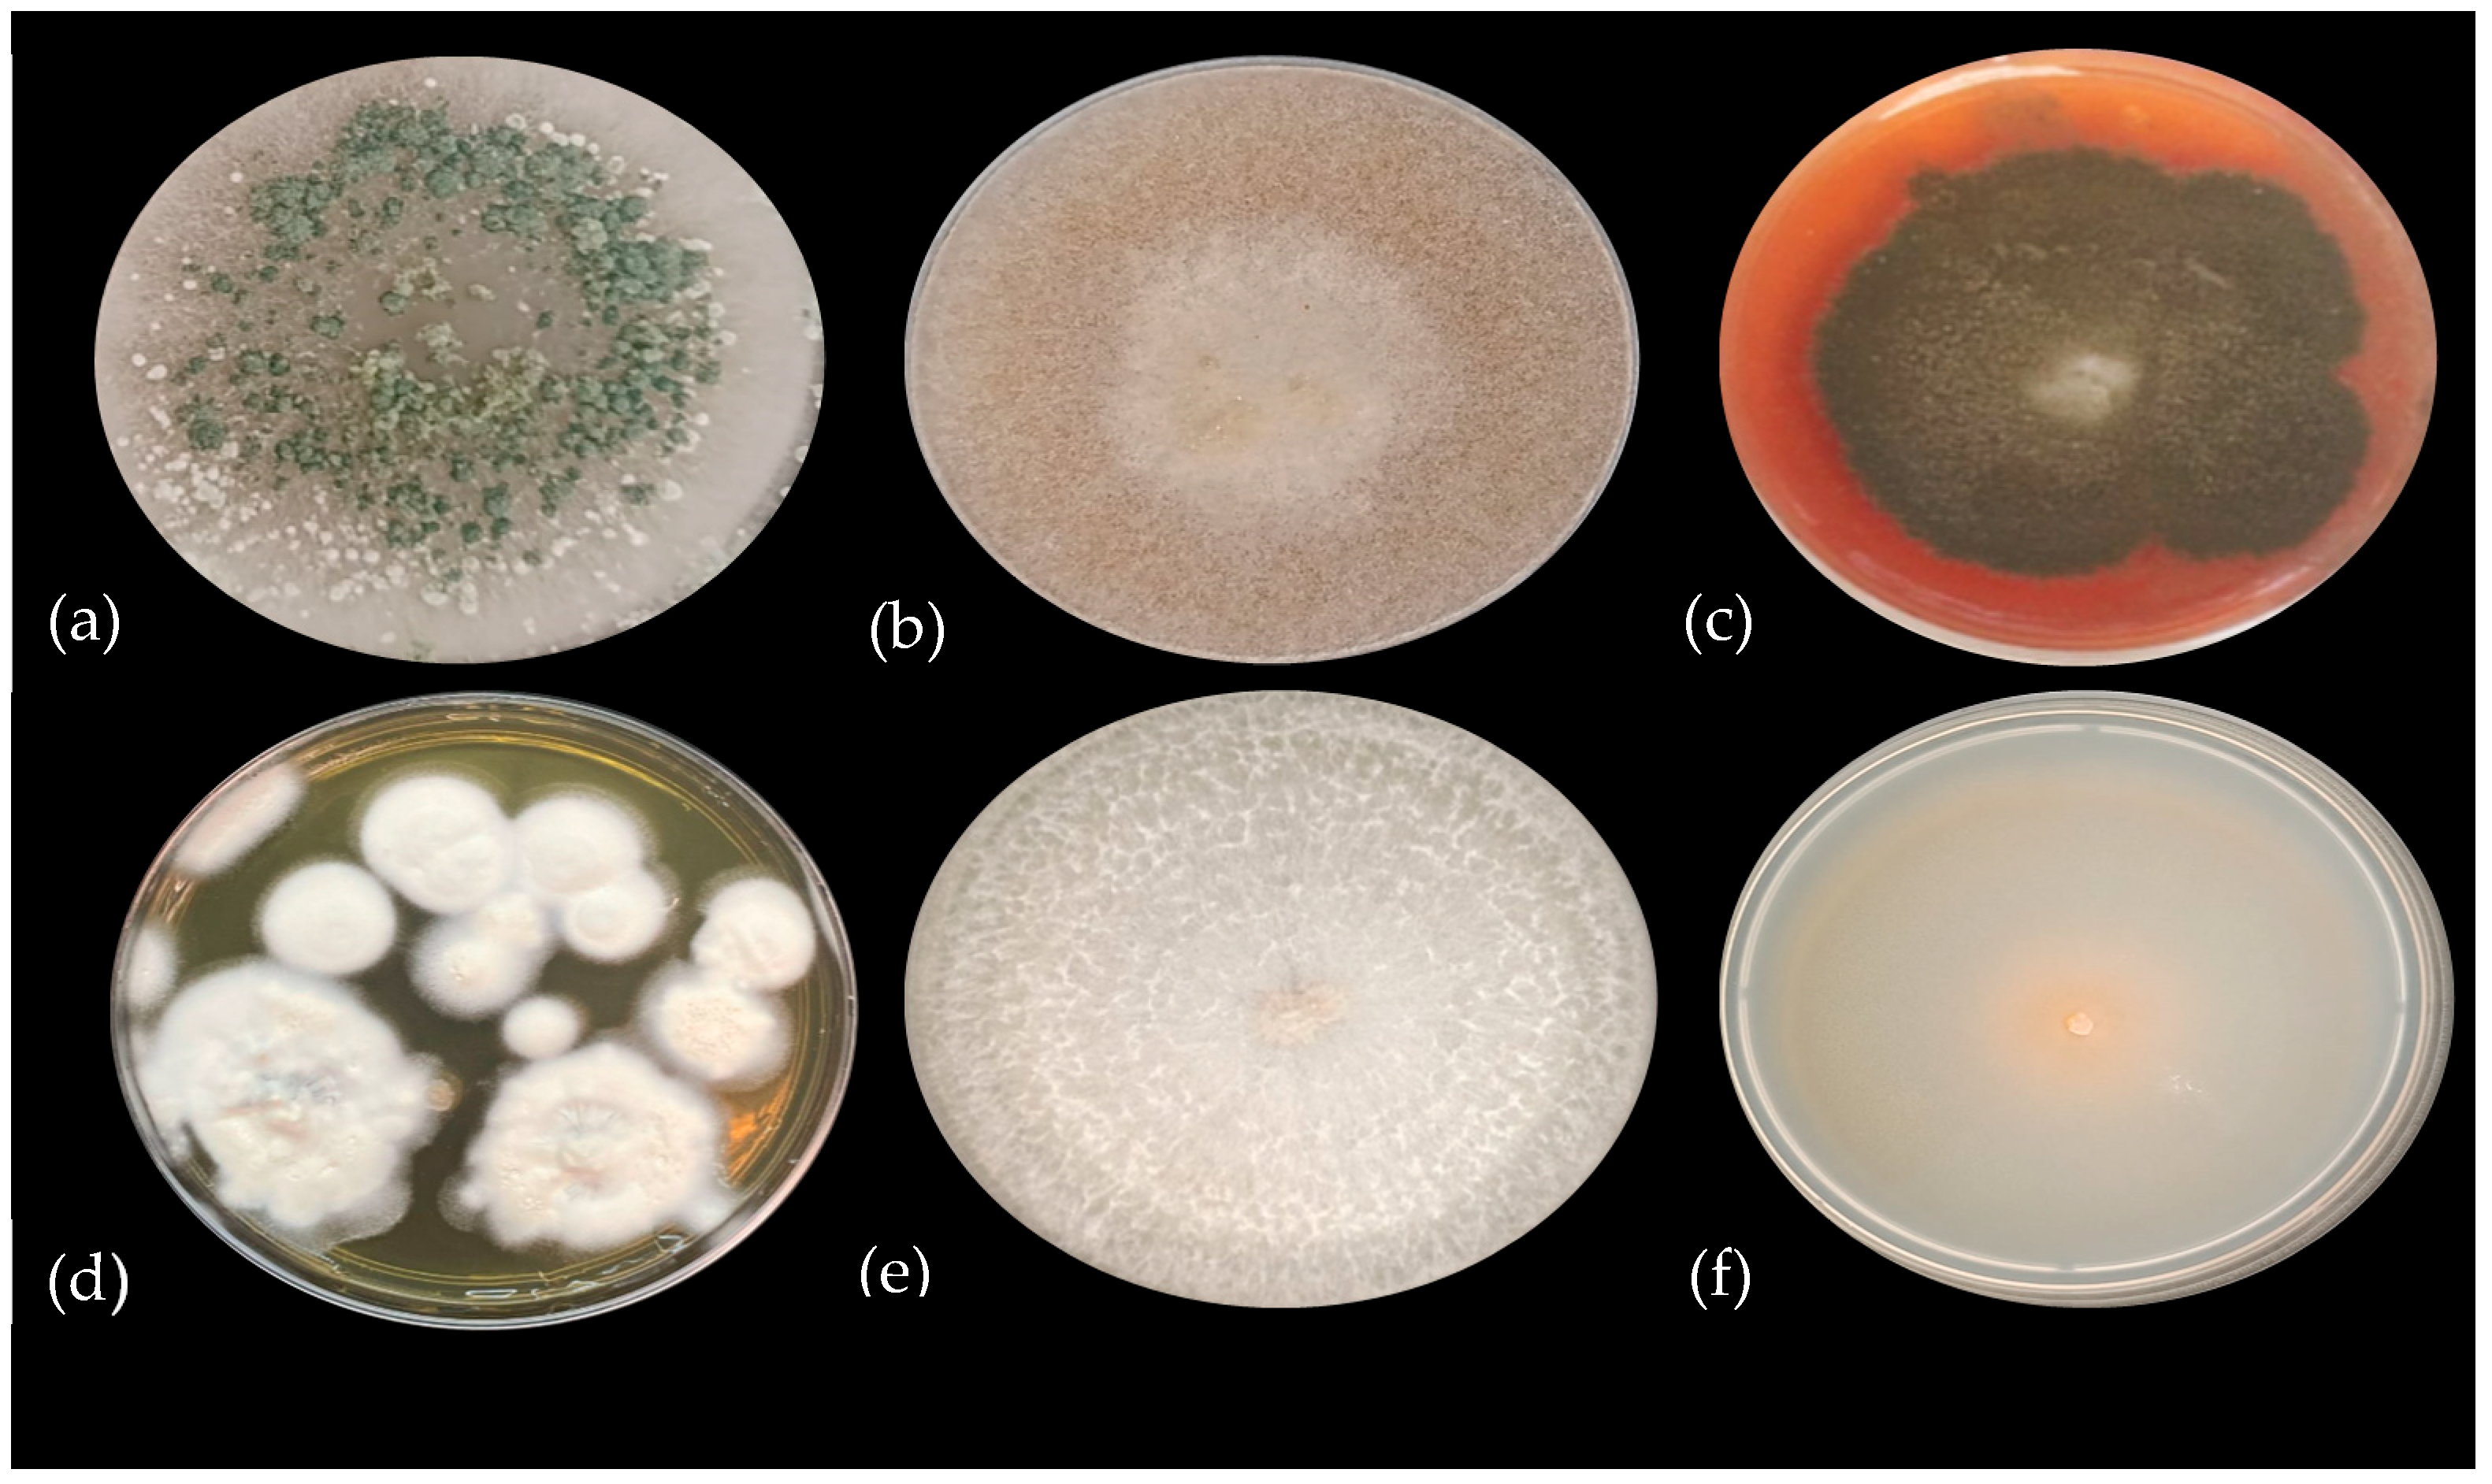
Microbiolres 16 00162 g002 Microbiolres 16 00162 g002

Selection and Evaluation of Phosphate-Solubilizing Fungal Consortia Inoculated into Three Varieties of Coffea arabica Under Greenhouse Conditions
Abstract
1. Introduction
2. Materials and Methods
2.1. Reactivation of PSF Strains
2.2. Molecular Identification of PSF Strains
2.3. Selecting Compatible Consortia
- % MI = percentage of mycelial inhibition;
- FMG = free mycelial growth (cm);
- IMG = influenced mycelial growth (cm).
2.4. Phosphate-Solubilizing Capacity of Individual and Consortium Strains
2.5. Acid Phosphatase Activity
2.6. Inoculation of PSF on Plants of Different Coffee Varieties
2.7. Available P in Soil and Total Foliar P
2.8. Inoculation Response Index
2.9. Statistical Analysis
3. Results
3.1. Identification of PSF Strains
3.2. Consortia Compatibility
3.3. Available P In Vitro
3.4. Quantification of Acid Phosphatase Activity
3.5. P Availability in the Rhizosphere
3.6. PSF Inoculation Response Index (RI)
4. Discussion
Author Contributions
Funding
Institutional Review Board Statement
Informed Consent Statement
Data Availability Statement
Acknowledgments
Conflicts of Interest
References
- SIAP (Servicio de Información Agroalimentaria y Pesquera). Available online: https://www.gob.mx/cms/uploads/attachment/file/938476/Caf__Julio.pdf (accessed on 19 March 2025).
- SADER (Secretaría de Agricultura, Ganadería, Desarrollo Rural, Pesca y Alimentación). Available online: https://www.gob.mx/agricultura/es/articulos/cafe-delicioso-producto-del-campo-mexicano?idiom=es (accessed on 19 March 2025).
- Geissert, D.; Ibáñez, A. Agroecosistemas cafetaleros del estado de Veracruz biodiversidad, manejo y conservación. In Calidad y Ambiente Físico-Químico de Los Suelos; Scribd: San Francisco, CA, USA, 2008; Capítulo 8; pp. 15–44. [Google Scholar]
- Richardson, A.E.; Simpson, R.J. Soil microorganisms mediating phosphorus availability update on microbial phosphorus. Plant physiol. 2011, 156, 989–996. [Google Scholar] [CrossRef] [PubMed]
- Beltrán-Pineda, M.E. Phosphate solubilization as a microbial strategy for promoting plant growth. Cienc. Tecnol. Agropecuaria. 2014, 15, 101–113. [Google Scholar]
- Nannipieri, P.; Giagnoni, L.; Landi, L.; Renella, G. Role of phosphatase enzymes in soil. In Phosphorus in Action. Soil Biology; Bünemann, E., Oberson, A., Frossard, E., Eds.; Springer: Berlin/Heidelberg, Germany, 2011; pp. 215–243. [Google Scholar] [CrossRef]
- Prabhu, N.; Borkar, S.; Garg, S. Phosphate solubilization by microorganisms: Overview, mechanisms, applications and advances. Advances in biological science research. In Advances in Biological Science Research: A Practical Approach Provides; Meena, S.N., Mohan, N.M., Eds.; Academic Press: Cambridge, MA, USA, 2019; pp. 161–176. [Google Scholar] [CrossRef]
- Shrivastava, M.; Srivastava, P.C.; D’Souza, S.F. Phosphate-Solubilizing Microbes: Diversity and Phosphates Solubilization Mechanism. In Role of Rhizospheric Microbes in Soil; Meena, V., Ed.; Springer: Berlin/Heidelberg, Germany, 2018. [Google Scholar] [CrossRef]
- Shen, Y.; Ma, Z.; Chen, H.; Lin, H.; Li, G.; Li, M.; Tan, D.; Gao, W.; Jiao, S.; Liu, P.; et al. Effects of macromolecular organic acids on reducing inorganic phosphorus fixation in soil. Heliyon 2023, 9, e14892. [Google Scholar] [CrossRef] [PubMed]
- Kishore, N.; Pindi, P.K.; Ram, R.S. Phosphate-solubilizing microorganisms: A critical review. In Plant Biology and Biotechnology; Bahadur, B., Venkat, R.M., Sahijram, L., Krishnamurthy, K., Eds.; Springer: New Delhi, India, 2015; pp. 307–333. [Google Scholar] [CrossRef]
- Chalfoun, S.M.; Angélico, C.L.; Resende, M.L.V.D.; Moraes, G.E.D. Selection of fungal isolates with potential for phosphate solubilation and formulation of inoculant for coffee crops. Coffee Sci. 2019, 14, 315–325. [Google Scholar] [CrossRef]
- Sembiring, M.; Sabrina, T.; Mukhlis, M. Phosphate solubilizing microbes and coffee skin compost to increase robusta coffee plant growth in Andisol of Mount Sinabung area. BJAS 2020, 26, 766–771. [Google Scholar]
- Abafita, R.; Assefa, F.; Muleta, D. Effect of phosphate solubilizing bio-inoculants and vermicompost application on mineral uptake and growth of coffee (Coffea arabica L.) seedlings under greenhouse condition. Ethiop. J. Biol. Sci. 2021, 44, 135–150. [Google Scholar] [CrossRef]
- Arias, R.M.; Heredia, G.; Perea, R.Y.C.; de la Cruz, E.Y.; García, G.K.Y. Selection and characterization of phosphate-solubilizing fungi and their effects on coffee plantations. Plants 2023, 12, 3395. [Google Scholar] [CrossRef] [PubMed]
- Perea-Rojas, Y.C.; Arias, R.M.; Medel, O.R.; Trejo, A.D.; Heredia, G.; Rodríguez, Y.Y. Effects of native arbuscular mycorrhizal and phosphate-solubilizing fungi on coffee plants. Agrofor. Syst. 2019, 93, 961–972. [Google Scholar] [CrossRef]
- Cisneros-Rojas, C.A.; Prager, S.D.; Menjivar-Flores, J.C. Effect of phosphate solubilizing bacteria on the development of coffee seedlings. Agron. Mesoam. 2017, 28, 149–158. [Google Scholar] [CrossRef]
- National Center for Biotechnology Information (NCBI). Available online: https://www.ncbi.nlm.nih.gov/nuccore/?term=Trichoderma+its+type (accessed on 19 January 2025).
- Rojas, B.J.A.; Hormaza, A.A. Evaluación del crecimiento y compatibilidad de hongos de la podredumbre blanca. Cienc. Des. 2014, 5, 197–205. [Google Scholar]
- Sundara, R.W.; Sinha, M.K. Phosphate dissolving organisms in the soil and rizosphere. Indian J. Sci. 1963, 33, 272–278. [Google Scholar]
- Clesceri, L.S.; Greenberg, A.E.; Trussell, R.R. Métodos Normalizados Para el Análisis de Aguas Potables y Residuales; Franson, M.A.H., Ed.; Ediciones Díaz de Santos, S.A.: Madrid, Spain, 1992; pp. 4–187. [Google Scholar]
- Tabatabai, M.A.; Bremner, J.M. Use of p-nitrophenyl phosphate for assay of soil phosphatase activity. Soil Biol. Biochem. 1969, 1, 301–307. [Google Scholar] [CrossRef]
- Souchie, E.; Azcón, R.; Barea, J.; Silva, E.; Saggin-Júnior, O. Enhancement of clover growth by inoculation of P-solubilizing fungi and arbuscular mycorrhizal fungi. An. Acad. Bras. Ciênc. 2010, 82, 771–777. [Google Scholar] [CrossRef] [PubMed]
- Bray, R.H.; Kurtz, L.T. Determination of total, organic and available forms of phosphorus in soil. Soil Sci. 1945, 59, 39–45. [Google Scholar] [CrossRef]
- McKean, S.J. Manual de Análisis de Suelos y Tejido Vegetal: Una Guía Teórica y Práctica de Metodologías; Centro Internacional de Agricultura Tropical: Cali-Palmira, Colombia, 1993; pp. 1–99. [Google Scholar]
- Plenchette, C.; Fortin, J.A.; Furlan, V. Growth response of several plant species to mycorrhiza in a soil of moderate P fertility I. Mycorrhizal dependency under field conditions. Plant Soil 1983, 70, 199–209. [Google Scholar] [CrossRef]
- Hoffmann, K. Identification of the Genus Absidia (Mucorales, Zygomycetes): A comprehensive taxonomic revision. In Molecular Identification of Fungi; Gherbawy, Y., Voigt, K., Eds.; Springer: Berlin/Heidelberg, Germany, 2010; pp. 439–460. [Google Scholar] [CrossRef]
- Liu-Xu, L.; Vicedo, B.; Papadopoulou, K.K.; Camañes, G.; Llorens, E. Isolation and characterization of a new Leptobacillium species promoting tomato plant growth. Sci. Rep. 2025, 15, 930. [Google Scholar] [CrossRef] [PubMed]
- Elias, F.; Woyessa, D.; Muleta, D. Phosphate solubilization potential of rhizosphere fungi isolated from plants in Jimma zone, Southwest Ethiopia. Int. J. Microbiol. 2016, 2016, 5472601. [Google Scholar] [CrossRef] [PubMed]
- Flood, J. Fusarium xylarioides (Marchitez del Café). CABI Compendium. 2023. Available online: https://www.cabi.org/cpc/datasheet/25166 (accessed on 25 February 2025).
- Khan, S.T. Consortia-based microbial inoculants for sustaining agricultural activities. Appl. Soil Ecol. 2022, 176, 104503. [Google Scholar] [CrossRef]
- Pal, S.; Singh, H.B.; Farooqui, A.; Rakshit, A. Fungal biofertilizers in Indian agriculture: Perception, demand and promotion. JEFA 2015, 10, 101–113. [Google Scholar]
- Khan, M.R.; Mohiddin, F.A. Trichoderma: Its multifarious utility in crop improvement. In New and Future Developments in Microbial Biotechnology and Bioengineering; Prasad, R., Sarvajeet, S.G., Narendra, T., Eds.; Elsevier: Amsterdam, The Netherlands, 2018; pp. 263–291. [Google Scholar] [CrossRef]
- Moreno, A.; Osorio, N.; González, O. In vitro dissolution of acidulated rock phosphate by phosphate solubilizing microorganisms. Acta Biol. Colomb. 2015, 20, 65–71. [Google Scholar] [CrossRef]
- Selvi, K.; Paul, J.; Vijaya, V.; Saraswathi, K. Analyzing the efficacy of phosphate solubilizing microorganisms by enrichment culture techniques. BMBJ 2017, 3, 1–7. [Google Scholar] [CrossRef][Green Version]
- Lima-Rivera, D.L.; Lopez-Lima, D.; Desgarennes, D.; Velazquez-Rodriguez, A.S.; Carrion, G. Phosphate solubilization by fungi with nematicidal potential. J. Soil Sci. Plant Nutr. 2016, 16, 507–524. [Google Scholar] [CrossRef]
- Jiang, Y.; Tian, J.; Ge, F. New Insight into Carboxylic Acid Metabolisms and pH Regulations During Insoluble Phosphate Solubilisation Process by Penicillium oxalicum PSF-4. Curr. Microbiol. 2020, 77, 4095–4103. [Google Scholar] [CrossRef] [PubMed]
- Vyas, P.; Rahi, P.; Chauhan, A.; Gulati, A. Phosphate solubilization potential and stress tolerance of Eupenicillium parvum from tea soil. Mycol. Res. 2004, 111, 931–938. [Google Scholar] [CrossRef] [PubMed]
- Gómez, Y. Actividad de las fosfatasas ácidas y alcalinas (extracelulares e intracelulares) en hongos de la rizosfera de Arachis hypogaea (Papiloneaceae). Rev. Biol. Trop. 2004, 52, 287–295. [Google Scholar] [CrossRef][Green Version]
- Anand, K.; Kumari, B.; Mallick, M. Phosphate solubilizing microbes: An effective and alternative approach as biofertilizers. Int. J. Pharm 2016, 8, 37–40. [Google Scholar] [CrossRef]
- Sadeghian, S. Fertilidad del Suelo y Nutrición del Café en Colombia: Guía Práctica. Available online: https://biblioteca.cenicafe.org/handle/10778/587 (accessed on 10 March 2025).
- Corrales, L.C.; Arévalo, Z.Y.; Moreno, V.E. Solubilización de fosfatos: Una función microbiana importante en el desarrollo vegetal. Nova 2014, 12, 68–79. [Google Scholar] [CrossRef]
- Napitupulu, T.P.; Ramadhani, I.; Kanti, A.; Sudiana, I.M. Diversity, phosphate solubilizing, and IAA production of culturable fungi associated with healthy and wilt banana. Arch. Phytopathol. Plant Prot. 2021, 54, 2306–2332. [Google Scholar] [CrossRef]
- Pedraza, R.O.; Bonilla, G.A.E.; Buitrago, R.R.B. Los Biofertilizantes y su Relación con la Sostenibilidad Agrícola. Available online: https://repository.agrosavia.co/handle/20.500.12324/36977 (accessed on 20 June 2025).
- Patiño, C.O.; Sanclemente, O.E. Los microorganismos solubilizadores de fósforo (MSF): Una alternativa biotecnológica para una agricultura sostenible. Entramado 2014, 10, 288–297. [Google Scholar]
- Moreno, N.; Moreno, L.; Uribe, D. Biofertilizantes para la agricultura en Colombia. In Biofertilizantes en Iberoamérica: Una Visión Técnica, Científica y Empresarial; Izaguirre-Mayoral, M.L., Labanderay, C., Sanjuán, J., Eds.; Editorial Universitaria: Santiago, Chile, 2007; pp. 38–45. [Google Scholar]

| Chemical Analysis | |
|---|---|
| pH | 4.29 |
| Total P (mg/kg) | 634.46 |
| Total nitrogen (%) | 0.35 |
| Organic matter (%) | 6 |
| Organic carbon (%) | 3.48 |
| Total carbon (%) | 3.69 |
| Treatments | PSF |
|---|---|
| C | No fungus |
| Y32 | Penicillium 32 |
| Y81 | Leptobacillium 81 |
| Y91 | Fusarium 91 |
| Y81+Y32 | Leptobacillium 81 + Penicillium 32 |
| Y91+Y32 | Fusarium 91 + Penicillium 32 |
| Y91+Y81 | Fusarium 91 + Leptobacillium 81 |
| Y32+Y81+Y91 | Penicillium 32 + Leptobacillium 81 + Fusarium 91 |
| Key | Species | Max Score | Query Cover (%) | Identity Score (%) | E Value | GenBank Accession Numbers |
|---|---|---|---|---|---|---|
| Y22 | Absidia sp. | - | - | - | - | - |
| Y91 | F. irregulare | 917 | 100 | 99.21 | 0.0 | PV750149 |
| Y85 | Fusarium crassum | 824 | 83 | 99.78 | 0.0 | PV750148 |
| Y81 | Leptobacillium leptobactrum | 974 | 97 | 99.44 | 0.0 | PV750150 |
| Y32 | Penicillium brevicompactum | 933 | 97 | 99.04 | 0.0 | PV750151 |
| Y19 | Trichoderma spirale | 1059 | 97 | 99.32 | 0.0 | PV750152 |
| Combinations | Inhibition Percentage (%) |
|---|---|
| Y91+Y19 | 100 |
| Y91+Y22 | 38.68 1 |
| Y91+Y32 | 15.65 1 |
| Y91+Y85 | 51.93 1 |
| Y91+Y81 | 50.2 1 |
| Y85+Y19 | 100 |
| Y85+Y22 | 46.5 1 |
| Y85+Y32 | 34.28 1 |
| Y85+Y81 | 45.28 1 |
| Y32+Y19 | 100 |
| Y32+Y22 | 50.17 1 |
| Y32+Y81 | 45.49 1 |
| Y81+Y19 | 100 |
| Y81+Y22 | 49.14 1 |
| Y19+Y22 | 20.11 1 |
| Anacafe Variety (RI %) | ||||||
| Treatments | Root length | Leaf dry biomass | Leaf area | Leaf P | Height | Stem diameter |
| Y32 | −19.93 | 220.65 | 68.57 | 4.28 | 65.52 | 23 |
| Y81 | −17.74 | 177.73 | 76.5 | 3.05 | 67.24 | 7 |
| Y91 | −18.34 | 249.8 | 79.89 | −0.22 | 65.57 | 31 |
| Y81+Y32 | −17.23 | 298.38 | 92.07 | 3.6 | 65.53 | 36 |
| Y91+Y81 | −13.92 | 161.54 | 63.96 | −14.31 | 65.51 | 19 |
| Y91+Y32 | −5.71 | 121.46 | 57.74 | 8.41 | 65.72 | 18 |
| Y32+Y81+Y91 | −5.11 | 177.73 | 89.66 | 9.56 | 82.7 | 23 |
| Costa Rica Variety (RI %) | ||||||
| Treatments | Root length | Leaf dry biomass | Leaf area | Leaf P | Height | Stem diameter |
| Y32 | −5.62 | 37.6 | 74.65 | 3.79 | 5.92 | 24.57 |
| Y81 | 7.06 | 128.4 | 139.81 | −10.43 | 3.95 | 27.96 |
| Y91 | 21.13 | 119.2 | 154.17 | 5.77 | 9.2 | 22.03 |
| Y81+Y32 | 11.28 | 125.6 | 174.6 | 6.56 | 7.9 | 12.71 |
| Y91+Y81 | 11.28 | 40 | 95.55 | 4.87 | 13.58 | 24.57 |
| Y91+Y32 | −2.79 | 205.2 | 249.51 | −0.82 | 23.69 | 26.27 |
| Y32+Y81+Y91 | 4.23 | 94.8 | 134.27 | 10.84 | 6.59 | 4.23 |
| Marsellesa Variety (RI %) | ||||||
| Treatments | Root length | Leaf dry biomass | Leaf area | Leaf P | Height | Stem diameter |
| Y32 | 60.42 | 237.69 | 101.88 | −0.95 | 33.66 | 386.67 |
| Y81 | 57.59 | 269.35 | 107.55 | −3.48 | 36.62 | 436.67 |
| Y91 | 50.96 | 128.14 | 112.13 | 2.38 | 28.17 | 370 |
| Y81+Y32 | 67.95 | 227.14 | 205.48 | −0.56 | 34.51 | 396.67 |
| Y91+Y81 | 96.26 | 192.46 | 165.35 | 2.69 | 35.21 | 393.33 |
| Y91+Y32 | 64.21 | 139.2 | 89.77 | −10.3 | 25.35 | 406.67 |
| Y32+Y81+Y91 | 62.29 | 148.24 | 139.93 | −5.51 | 22.54 | 460 |
Disclaimer/Publisher’s Note: The statements, opinions and data contained in all publications are solely those of the individual author(s) and contributor(s) and not of MDPI and/or the editor(s). MDPI and/or the editor(s) disclaim responsibility for any injury to people or property resulting from any ideas, methods, instructions or products referred to in the content. |
© 2025 by the authors. Licensee MDPI, Basel, Switzerland. This article is an open access article distributed under the terms and conditions of the Creative Commons Attribution (CC BY) license (https://creativecommons.org/licenses/by/4.0/).
Share and Cite
Perea-Rojas, Y.d.C.; Arias, R.M.; Medel-Ortíz, R. Selection and Evaluation of Phosphate-Solubilizing Fungal Consortia Inoculated into Three Varieties of Coffea arabica Under Greenhouse Conditions. Microbiol. Res. 2025, 16, 162. https://doi.org/10.3390/microbiolres16070162
Perea-Rojas YdC, Arias RM, Medel-Ortíz R. Selection and Evaluation of Phosphate-Solubilizing Fungal Consortia Inoculated into Three Varieties of Coffea arabica Under Greenhouse Conditions. Microbiology Research. 2025; 16(7):162. https://doi.org/10.3390/microbiolres16070162
Chicago/Turabian StylePerea-Rojas, Yamel del Carmen, Rosa María Arias, and Rosario Medel-Ortíz. 2025. "Selection and Evaluation of Phosphate-Solubilizing Fungal Consortia Inoculated into Three Varieties of Coffea arabica Under Greenhouse Conditions" Microbiology Research 16, no. 7: 162. https://doi.org/10.3390/microbiolres16070162
APA StylePerea-Rojas, Y. d. C., Arias, R. M., & Medel-Ortíz, R. (2025). Selection and Evaluation of Phosphate-Solubilizing Fungal Consortia Inoculated into Three Varieties of Coffea arabica Under Greenhouse Conditions. Microbiology Research, 16(7), 162. https://doi.org/10.3390/microbiolres16070162

